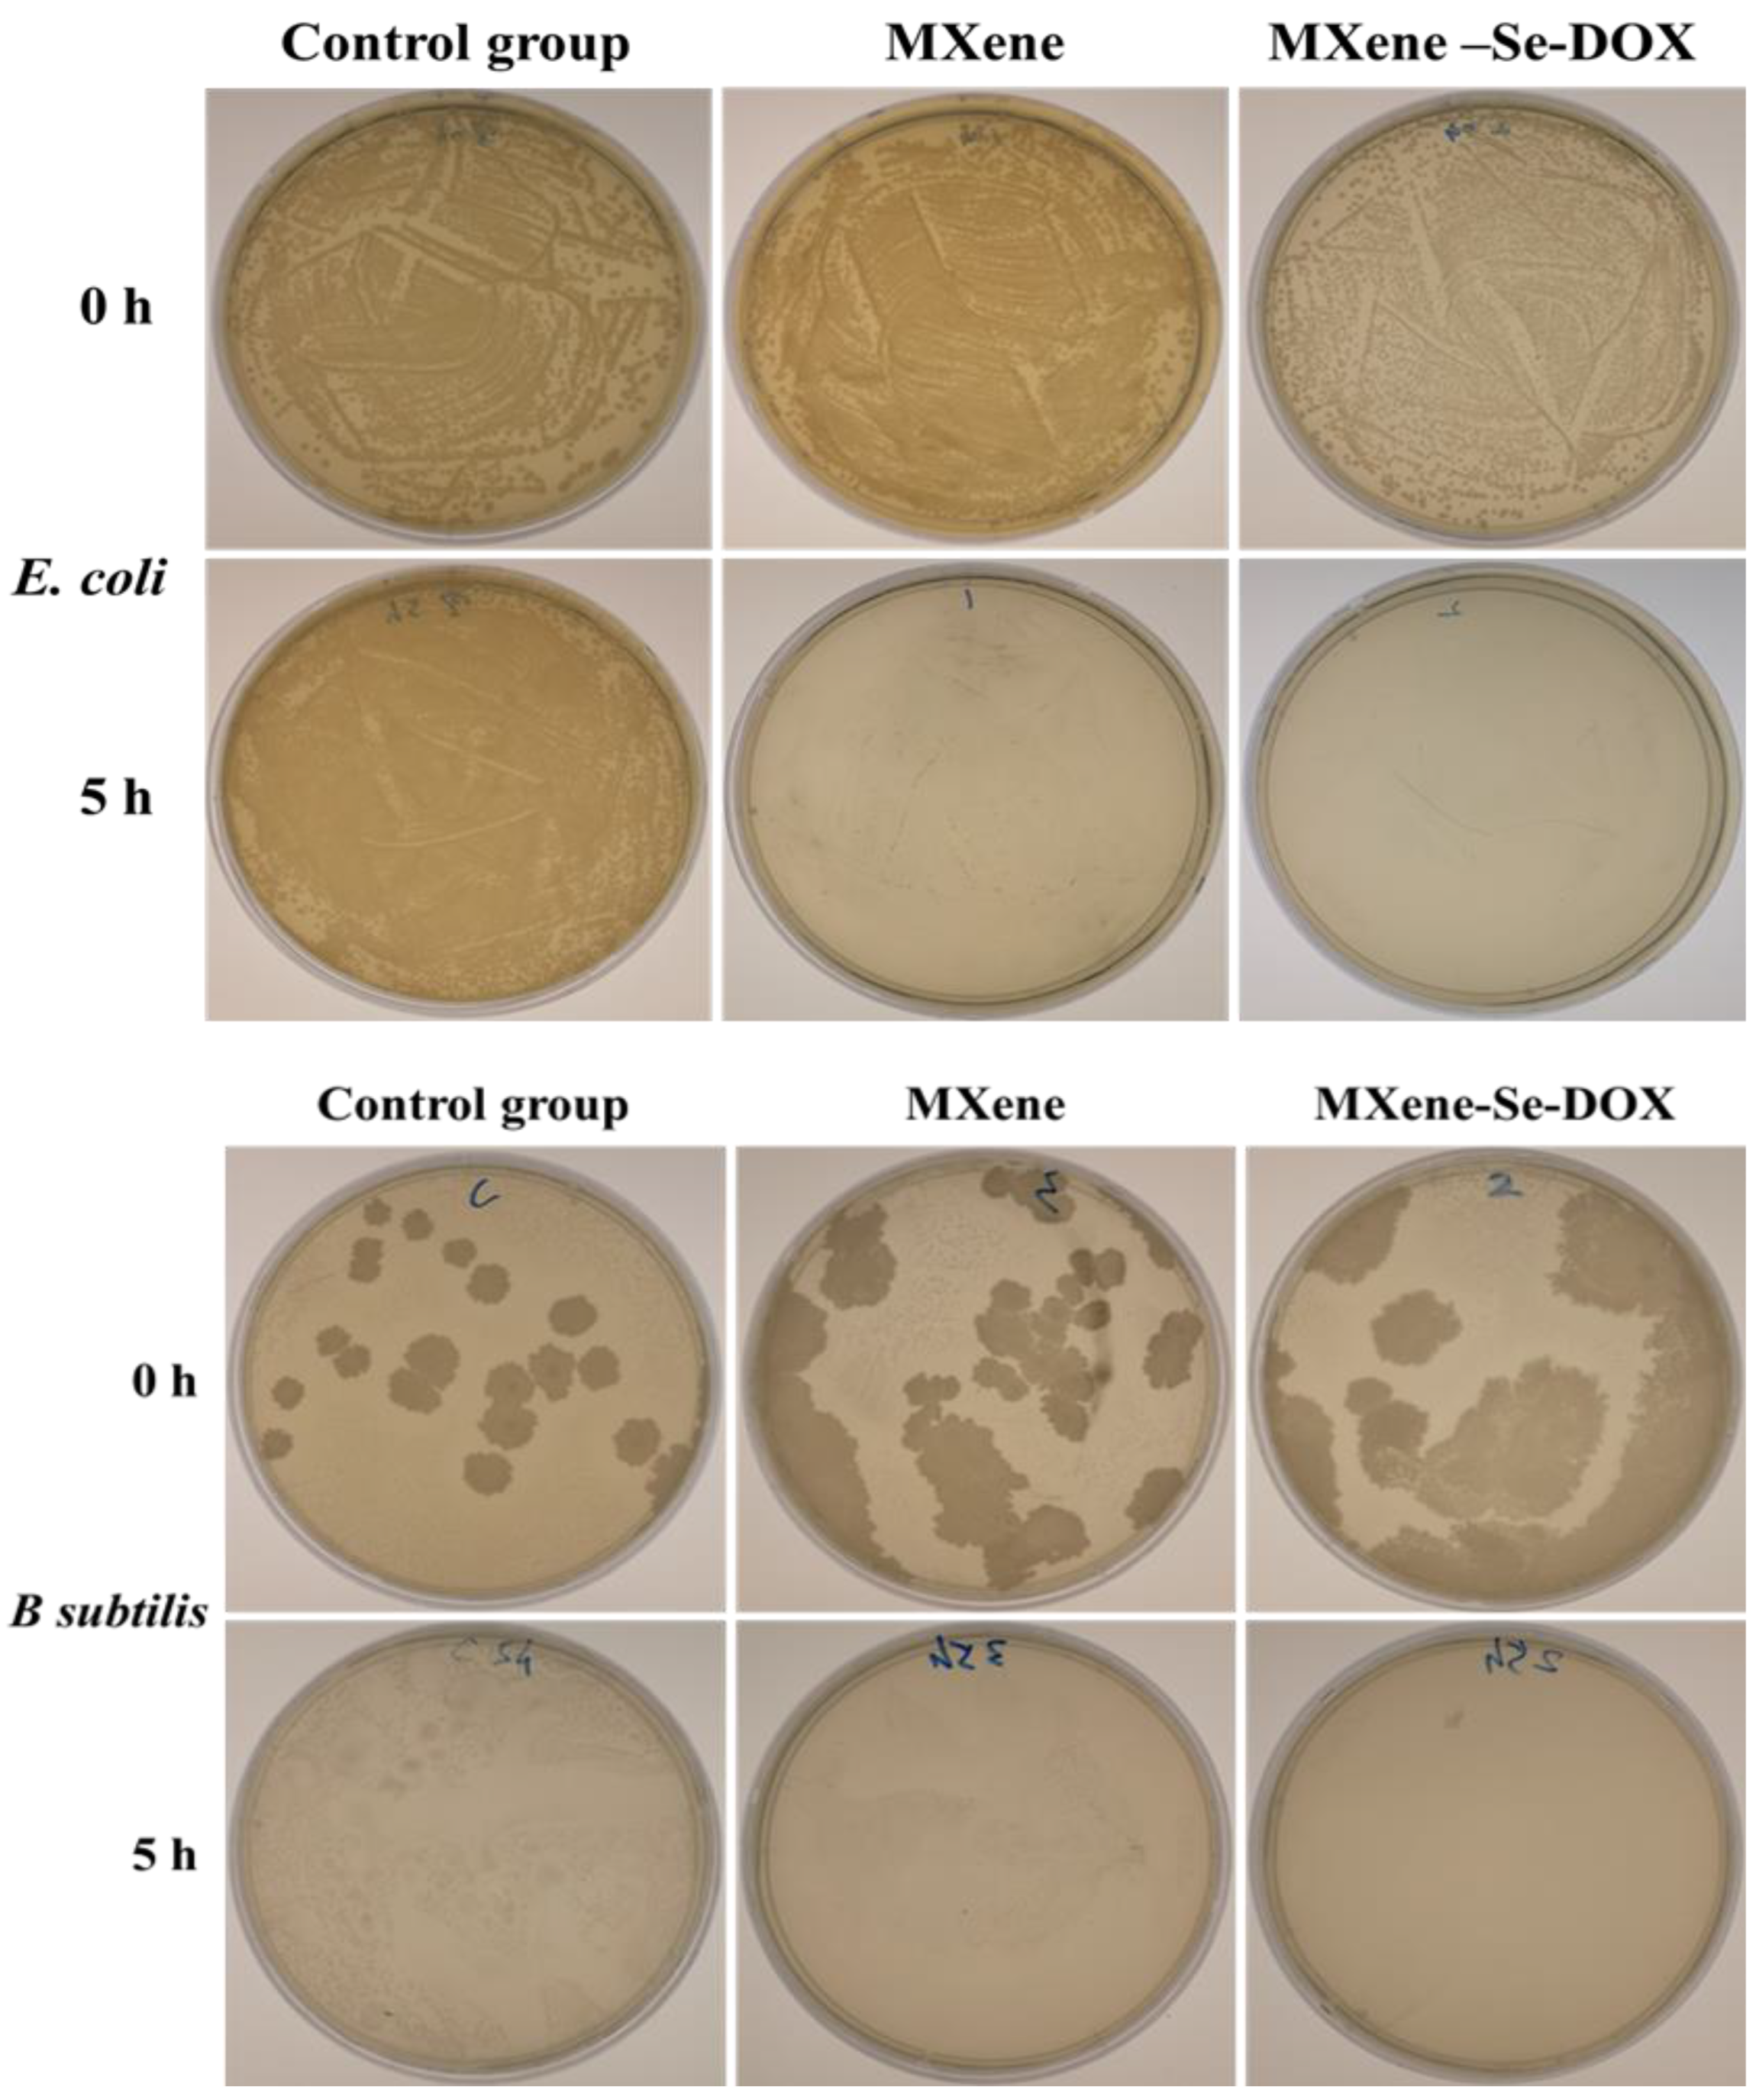
Ijms 23 14925 g006

Dual (pH- and ROS-) Responsive Antibacterial MXene-Based Nanocarrier for Drug Delivery
Abstract
:1. Introduction
2. Results and Discussion
2.1. FTIR and Raman Spectra
2.2. Physicochemical Analysis
2.3. Morphology
2.4. XPS Spectra
2.5. In Vitro Antibacterial Activity
2.6. In Vitro Drug Release Profile
2.7. Drug Release Kinetics
3. Materials and Method
3.1. Materials
3.2. Characterization
3.3. Synthesis of MXene Nanosheets
3.4. Synthesis of MXene-NH2 Nanosheets
3.5. Synthesis of 3,3′-Diselanediyldipropionic Acid
3.6. Synthesis of MXene-Se Nanosheets
3.7. Synthesis of MXene-Se-DOX Nanosheets
3.8. Antibacterial Activity
3.9. Loading Capacity and Drug Release Study
4. Conclusions
Supplementary Materials
Author Contributions
Funding
Institutional Review Board Statement
Informed Consent Statement
Data Availability Statement
Conflicts of Interest
References
- Naguib, M.; Gogotsi, Y. Synthesis of two-dimensional materials by selective extraction. Acc. Chem. Res. 2015, 48, 128–135. [Google Scholar] [CrossRef] [PubMed]
- Tian, J.; Ji, G.; Han, X.; Xing, F.; Gao, Q. Advanced Nanostructured MXene-Based Materials for High Energy Density Lithium–Sulfur Batteries. Int. J. Mol. Sci. 2022, 23, 6329. [Google Scholar] [CrossRef] [PubMed]
- Ghidiu, M.; Lukatskaya, M.R.; Zhao, M.-Q.; Gogotsi, Y.; Barsoum, M.W. Conductive two-dimensional titanium carbide ‘clay’with high volumetric capacitance. Nature 2014, 516, 78–81. [Google Scholar] [CrossRef] [PubMed]
- Ramanavicius, S.; Ramanavicius, A. Progress and insights in the application of MXenes as new 2D nano-materials suitable for biosensors and biofuel cell design. Int. J. Mol. Sci. 2020, 21, 9224. [Google Scholar] [CrossRef]
- Han, X.; Huang, J.; Lin, H.; Wang, Z.; Li, P.; Chen, Y. 2D ultrathin MXene-based drug-delivery nanoplatform for synergistic photothermal ablation and chemotherapy of cancer. Adv. Healthc. Mater. 2018, 7, 1701394. [Google Scholar] [CrossRef]
- Singh, S.K.; Singh, A.; Kumar, V.; Gupta, J.; Umrao, S.; Kumar, M.; Verma, V. Nanosheets Based Approach to Elevate the Proliferative and Differentiation Efficacy of Human Wharton’s Jelly Mesenchymal Stem Cells. Int. J. Mol. Sci. 2022, 23, 5816. [Google Scholar] [CrossRef]
- Naguib, M.; Kurtoglu, M.; Presser, V.; Lu, J.; Niu, J.; Heon, M.; Hultman, L.; Gogotsi, Y.; Barsoum, M.W. Two-dimensional nanocrystals produced by exfoliation of Ti3AlC2. Adv. Mater. 2011, 23, 4248–4253. [Google Scholar] [CrossRef] [Green Version]
- Cao, Y.; Wu, T.; Zhang, K.; Meng, X.; Dai, W.; Wang, D.; Dong, H.; Zhang, X. Engineered exosome-mediated near-infrared-II region V2C quantum dot delivery for nucleus-target low-temperature photothermal therapy. ACS Nano 2019, 13, 1499–1510. [Google Scholar] [CrossRef]
- Sung, H.; Ferlay, J.; Siegel, R.L.; Laversanne, M.; Soerjomataram, I.; Jemal, A.; Bray, F. Global cancer statistics 2020: GLOBOCAN estimates of incidence and mortality worldwide for 36 cancers in 185 countries. CA Cancer J. Clin. 2021, 71, 209–249. [Google Scholar] [CrossRef]
- Miller, K.D.; Nogueira, L.; Mariotto, A.B.; Rowland, J.H.; Yabroff, K.R.; Alfano, C.M.; Jemal, A.; Kramer, J.L.; Siegel, R.L. Cancer treatment and survivorship statistics, 2019. CA Cancer J. Clin. 2019, 69, 363–385. [Google Scholar] [CrossRef] [PubMed]
- Siegel, R.L.; Miller, K.D.; Fuchs, H.E.; Jemal, A. Cancer statistics, 2021. CA Cancer J. Clin. 2021, 71, 7–33. [Google Scholar] [CrossRef]
- Chaturvedi, V.K.; Singh, A.; Singh, V.K.; Singh, M.P. Cancer nanotechnology: A new revolution for cancer diagnosis and therapy. Curr. Drug Metab. 2019, 20, 416–429. [Google Scholar] [CrossRef] [PubMed]
- Sun, Q.; Zhou, Z.; Qiu, N.; Shen, Y. Rational design of cancer nanomedicine: Nanoproperty integration and synchronization. Adv. Mater. 2017, 29, 1606628. [Google Scholar] [CrossRef] [PubMed]
- Xu, X.; Saw, P.E.; Tao, W.; Li, Y.; Ji, X.; Bhasin, S.; Liu, Y.; Ayyash, D.; Rasmussen, J.; Huo, M. ROS-responsive polyprodrug nanoparticles for triggered drug delivery and effective cancer therapy. Adv. Mater. 2017, 29, 1700141. [Google Scholar] [CrossRef] [PubMed] [Green Version]
- Rasool, K.; Helal, M.; Ali, A.; Ren, C.E.; Gogotsi, Y.; Mahmoud, K.A. Antibacterial activity of Ti3C2Tx MXene. ACS Nano 2016, 10, 3674–3684. [Google Scholar] [CrossRef] [PubMed] [Green Version]
- Chu, B.; Qu, Y.; He, X.; Hao, Y.; Yang, C.; Yang, Y.; Hu, D.; Wang, F.; Qian, Z. ROS-responsive camptothecin prodrug nanoparticles for on-demand drug Release and combination of chemotherapy and photodynamic therapy. Adv. Funct. Mater. 2020, 30, 2005918. [Google Scholar] [CrossRef]
- Zhu, Y.; Wang, Z.; Zhao, R.; Zhou, Y.; Feng, L.; Gai, S.; Yang, P. Pt Decorated Ti3C2Tx MXene with NIR-II Light Amplified Nanozyme Catalytic Activity for Efficient Phototheranostics. ACS Nano 2022, 16, 3105–3118. [Google Scholar] [CrossRef]
- Zhang, W.-J.; Yan, Y.-Z.; Nagappan, S.; He, S.; Ha, C.-S.; Jin, Y.-S. Dual (thermo-/pH-) responsive P (NIPAM-co-AA-co-HEMA) nanocapsules for controlled release of 5-fluorouracil. J. Macromol. Sci. A 2021, 58, 860–871. [Google Scholar] [CrossRef]
- Xu, X.-D.; Cheng, Y.-J.; Wu, J.; Cheng, H.; Cheng, S.-X.; Zhuo, R.-X.; Zhang, X.-Z. Smart and hyper-fast responsive polyprodrug nanoplatform for targeted cancer therapy. Biomaterials 2016, 76, 238–249. [Google Scholar] [CrossRef]
- Dong, J.-H.; Ma, Y.; Li, R.; Zhang, W.-T.; Zhang, M.-Q.; Meng, F.-N.; Ding, K.; Jiang, H.-T.; Gong, Y.-K. Smart MSN-drug-delivery system for tumor cell targeting and tumor microenvironment release. ACS Appl. Mater. Interfaces 2021, 13, 42522–42532. [Google Scholar] [CrossRef]
- Li, J.; Ke, W.; Wang, L.; Huang, M.; Yin, W.; Zhang, P.; Chen, Q.; Ge, Z. Self-sufficing H2O2-responsive nanocarriers through tumor-specific H2O2 production for synergistic oxidation-chemotherapy. J. Control. Release 2016, 225, 64–74. [Google Scholar] [CrossRef] [PubMed]
- Mahmoudi, M.; Lynch, I.; Ejtehadi, M.R.; Monopoli, M.P.; Bombelli, F.B.; Laurent, S. Protein-nanoparticle interactions: Opportunities and challenges. Chem. Rev. 2011, 111, 5610–5637. [Google Scholar] [CrossRef] [PubMed]
- Zhao, J.; Chai, Y.-D.; Zhang, J.; Huang, P.-F.; Nakashima, K.; Gong, Y.-K. Long circulating micelles of an amphiphilic random copolymer bearing cell outer membrane phosphorylcholine zwitterions. Acta Biomater. 2015, 16, 94–102. [Google Scholar] [CrossRef] [PubMed]
- Qu, Y.; Chu, B.; Wei, X.; Lei, M.; Hu, D.; Zha, R.; Zhong, L.; Wang, M.; Wang, F.; Qian, Z. Redox/pH dual-stimuli responsive camptothecin prodrug nanogels for “on-demand” drug delivery. J. Control. Release 2019, 296, 93–106. [Google Scholar] [CrossRef]
- Hu, X.; Liu, G.; Li, Y.; Wang, X.; Liu, S. Cell-penetrating hyperbranched polyprodrug amphiphiles for synergistic reductive milieu-triggered drug release and enhanced magnetic resonance signals. J. Am. Chem. Soc. 2015, 137, 362–368. [Google Scholar] [CrossRef]
- Rasool, K.; Mahmoud, K.A.; Johnson, D.J.; Helal, M.; Berdiyorov, G.R.; Gogotsi, Y. Efficient antibacterial membrane based on two-dimensional Ti3C2Tx (MXene) nanosheets. Sci. Rep. 2017, 7, 1–11. [Google Scholar] [CrossRef]
- Pokhrel, J.; Bhoria, N.; Anastasiou, S.; Tsoufis, T.; Gournis, D.; Romanos, G.; Karanikolos, G.N. CO2 adsorption behavior of amine-functionalized ZIF-8, graphene oxide, and ZIF-8/graphene oxide composites under dry and wet conditions. Microporous Mesoporous Mater. 2018, 267, 53–67. [Google Scholar] [CrossRef]
- Sun, S.; Sha, X.; Liang, J.; Yang, G.; Hu, X.; He, Z.; Liu, M.; Zhou, N.; Zhang, X.; Wei, Y. Rapid synthesis of polyimidazole functionalized MXene via microwave-irradiation assisted multi-component reaction and its iodine adsorption performance. J. Hazard. Mater. 2021, 420, 126580. [Google Scholar] [CrossRef]
- Pan, Q.-S.; Chen, T.-T.; Nie, C.-P.; Yi, J.-T.; Liu, C.; Hu, Y.-L.; Chu, X. In situ synthesis of ultrathin ZIF-8 film-coated MSNs for codelivering Bcl 2 siRNA and doxorubicin to enhance chemotherapeutic efficacy in drug-resistant cancer cells. ACS Appl. Mater. Interfaces 2018, 10, 33070–33077. [Google Scholar] [CrossRef]
- She, X.; Chen, L.; Velleman, L.; Li, C.; Zhu, H.; He, C.; Wang, T.; Shigdar, S.; Duan, W.; Kong, L. Fabrication of high specificity hollow mesoporous silica nanoparticles assisted by Eudragit for targeted drug delivery. J. Colloid Interface Sci. 2015, 445, 151–160. [Google Scholar] [CrossRef]
- Chen, J.; Yuan, X.; Lyu, F.; Zhong, Q.; Hu, H.; Pan, Q.; Zhang, Q. Integrating MXene nanosheets with cobalt-tipped carbon nanotubes for an efficient oxygen reduction reaction. J. Mater. Chem. 2019, 7, 1281–1286. [Google Scholar] [CrossRef]
- Urso, M.; Ussia, M.; Novotný, F.; Pumera, M. Trapping and detecting nanoplastics by MXene-derived oxide microrobots. Nat. Commun. 2022, 13, 1–14. [Google Scholar] [CrossRef]
- Iqbal, A.; Hamdan, N.M. Investigation and Optimization of MXene Functionalized Mesoporous Titania Films as Efficient Photoelectrodes. Mater. 2021, 14, 6292. [Google Scholar] [CrossRef] [PubMed]
- Nam, S.; Umrao, S.; Oh, S.; Shin, K.H.; Park, H.S.; Oh, I.-K. Sonochemical self-growth of functionalized titanium carbide nanorods on Ti3C2 nanosheets for high capacity anode for lithium-ion batteries. Compos. B. Eng. 2020, 181, 107583. [Google Scholar] [CrossRef]
- Lu, B.; Hu, S.; Wu, D.; Wu, C.; Zhu, Z.; Hu, L.; Zhang, J. Ionic liquid exfoliated Ti3C2Tx MXene nanosheets for photoacoustic imaging and synergistic photothermal/chemotherapy of cancer. J. Mater. Chem. B 2022, 10, 1226–1235. [Google Scholar] [CrossRef]
- Liu, X.; Qiu, Y.; Jiang, D.; Li, F.; Gan, Y.; Zhu, Y.; Pan, Y.; Wan, H.; Wang, P. Covalently grafting first-generation PAMAM dendrimers onto MXenes with self-adsorbed AuNPs for use as a functional nanoplatform for highly sensitive electrochemical biosensing of cTnT. Microsyst. Nanoeng. 2022, 8, 1–15. [Google Scholar] [CrossRef]
- Li, X.; Kim, J.; Yoon, J.; Chen, X. Cancer-associated, stimuli-driven, turn on theranostics for multimodality imaging and therapy. Adv. Mater. 2017, 29, 1606857. [Google Scholar] [CrossRef]
- Zhou, B.; Song, J.; Wang, B.; Feng, Y.; Liu, C.; Shen, C. Robust double-layered ANF/MXene-PEDOT: PSS Janus films with excellent multi-source driven heating and electromagnetic interference shielding properties. Nano Res. 2022, 15, 9520–9530. [Google Scholar] [CrossRef]
- Rohani, S.; Mohammadi Ziarani, G.; Badiei, A.; Ziarati, A.; Jafari, M.; Shayesteh, A. Palladium-anchored multidentate SBA-15/di-urea nanoreactor: A highly active catalyst for Suzuki coupling reaction. Adv. Organomet. Chem. 2018, 32, e4397. [Google Scholar] [CrossRef]
- Liu, Y.; He, Y.; Vargun, E.; Plachy, T.; Saha, P.; Cheng, Q. 3D porous Ti3C2 MXene/NiCo-MOF composites for enhanced lithium storage. Nanomaterials 2020, 10, 695. [Google Scholar] [CrossRef]
- Cao, M.; Wang, F.; Wang, L.; Wu, W.; Lv, W.; Zhu, J. Room temperature oxidation of Ti3C2 MXene for supercapacitor electrodes. J. Electrochem. Soc. 2017, 164, A3933. [Google Scholar] [CrossRef]
- Tian, W.; VahidMohammadi, A.; Wang, Z.; Ouyang, L.; Beidaghi, M.; Hamedi, M.M. Layer-by-layer self-assembly of pillared two-dimensional multilayers. Nat. Commun. 2019, 10, 1–10. [Google Scholar] [CrossRef] [PubMed] [Green Version]
- Ravi, S.; Zhang, S.; Lee, Y.R.; Kang, K.K.; Kim, J.M.; Ahn, J.W.; Ahn, W.S. EDTA-functionalized KCC-1 and KIT-6 mesoporous silicas for Nd3+ ion recovery from aqueous solutions. J. Ind. Eng. Chem. 2018, 67, 210–218. [Google Scholar] [CrossRef]
- Zheng, K.; Li, S.; Jing, L.; Chen, P.Y.; Xie, J. Synergistic antimicrobial titanium carbide (MXene) conjugated with gold nanoclusters. Adv. Healthc. Mater. 2020, 9, 2001007. [Google Scholar] [CrossRef] [PubMed]
- Park, G.D.; Cho, J.S.; Lee, J.-K.; Kang, Y.C. Na-ion storage performances of FeSex and Fe2O3 hollow nanoparticles-decorated reduced graphene oxide balls prepared by nanoscale Kirkendall diffusion process. Sci. Rep. 2016, 6, 1–10. [Google Scholar] [CrossRef] [Green Version]
- Ji, J.; Zhao, L.; Shen, Y.; Liu, S.; Zhang, Y. Covalent stabilization and functionalization of MXene via silylation reactions with improved surface properties. FlatChem 2019, 17, 100128. [Google Scholar] [CrossRef]
- Pazniak, A.; Bazhin, P.; Shplis, N.; Kolesnikov, E.; Shchetinin, I.; Komissarov, A.; Polcak, J.; Stolin, A.; Kuznetsov, D. Ti3C2Tx MXene characterization produced from SHS-ground Ti3AlC2. Mater. Des. 2019, 183, 108143. [Google Scholar] [CrossRef]
- Choi, Y.S.; Huh, K.M.; Shim, M.S.; Park, I.S.; Cho, Y.Y.; Lee, J.Y.; Lee, H.S.; Kang, H.C. Disrupting the redox balance with a diselenide drug delivery system: Synergistic or antagonistic? Adv. Funct. Mater. 2021, 31, 2007275. [Google Scholar] [CrossRef]
- Halim, J.; Cook, K.M.; Naguib, M.; Eklund, P.; Gogotsi, Y.; Rosen, J.; Barsoum, M.W. X-ray photoelectron spectroscopy of select multi-layered transition metal carbides (MXenes). Appl. Surf. Sci. 2016, 362, 406–417. [Google Scholar] [CrossRef] [Green Version]
- Xiang, Y.; Zhang, G.; Chen, C.; Liu, B.; Cai, D.; Wu, Z. Fabrication of a pH-responsively controlled-release pesticide using an attapulgite-based hydrogel. ACS Sustain. Chem. Eng. 2018, 6, 1192–1201. [Google Scholar] [CrossRef]
- Porębska, D.; Orzeł, Ł.; Rutkowska-Zbik, D.; Stochel, G.; Van Eldik, R. Ligand-tuning of the stability of Pd (II) conjugates with cyanocobalamin. Int. J. Mol. Sci. 2021, 22, 7973. [Google Scholar] [CrossRef] [PubMed]
- Martinez-Erro, S.; Navas, F.; Romaní-Cubells, E.; Fernández-García, P.; Morales, V.; Sanz, R.; García-Muñoz, R.A. Kidney-protector lipidic cilastatin derivatives as structure-directing agents for the synthesis of mesoporous silica nanoparticles for drug delivery. Int. J. Mol. Sci. 2021, 22, 7968. [Google Scholar] [CrossRef] [PubMed]
- Abebe, E.; Gugsa, G.; Ahmed, M. Review on major food-borne zoonotic bacterial pathogens. Asian Pac. J. Trop. Med. 2020, 2020. [Google Scholar] [CrossRef] [PubMed]
- Kasiński, A.; Zielińska-Pisklak, M.; Kowalczyk, S.; Plichta, A.; Zgadzaj, A.; Oledzka, E.; Sobczak, M. Synthesis and characterization of new biodegradable injectable thermosensitive smart hydrogels for 5-fluorouracil delivery. Int. J. Mol. Sci. 2021, 22, 8330. [Google Scholar] [CrossRef]
- Yoo, J.-W.; Chambers, E.; Mitragotri, S. Factors that control the circulation time of nanoparticles in blood: Challenges, solutions and future prospects. Curr. Pharm. Des. 2010, 16, 2298–2307. [Google Scholar] [CrossRef]
- Rosenbrand, R.; Barata, D.; Sutthavas, P.; Mohren, R.; Cillero-Pastor, B.; Habibovic, P.; van Rijt, S. Lipid surface modifications increase mesoporous silica nanoparticle labeling properties in mesenchymal stem cells. Int. J. Nanomed. 2018, 13, 7711. [Google Scholar] [CrossRef] [Green Version]
- Encinas, N.; Angulo, M.; Astorga, C.; Colilla, M.; Izquierdo-Barba, I.; Vallet-Regí, M. Mixed-charge pseudo-zwitterionic mesoporous silica nanoparticles with low-fouling and reduced cell uptake properties. Acta Biomater. 2019, 84, 317–327. [Google Scholar] [CrossRef]
- Salma, S.A.; Patil, M.P.; Kim, D.W.; Le, C.M.Q.; Ahn, B.-H.; Kim, G.-D.; Lim, K.T. Near-infrared light-responsive, diselenide containing core-cross-linked micelles prepared by the Diels–Alder click reaction for photocontrollable drug release application. Polym. Chem. 2018, 9, 4813–4823. [Google Scholar] [CrossRef]

| Sample | Element At. % | ||||||
|---|---|---|---|---|---|---|---|
| Ti | C | O | F | N | Si | Se | |
| MXene | 7.36 | 28.23 | 12.58 | 50.59 | - | - | - |
| MXene-Se | 7.68 | 55.42 | 0.73 | 1.83 | 3.49 | 4.56 | 0.73 |
| MXene-Se-DOX | 6.54 | 54.09 | 28.62 | 1.44 | 3.57 | 4.34 | 0.29 |
| Sample Code | Release Medium | Korsmeyer–Peppas a | ||
|---|---|---|---|---|
| n | kp | R2 | ||
| pH 5.5 | 0.271 | 2.075 | 0.898 | |
| pH 7.4 | 0.096 | 0.713 | 0.937 | |
| pH 7.4 + H2O2 | 0.143 | 12.51 | 0.974 | |
| MXene-Se-DOX | pH 7.4 + GSH | 0.159 | 15.16 | 0.913 |
| pH 5.5 + H2O2 | 0.209 | 26.67 | 0.964 | |
| pH 5.5 + GSH | 0.201 | 32.52 | 0.979 | |
Publisher’s Note: MDPI stays neutral with regard to jurisdictional claims in published maps and institutional affiliations. |
© 2022 by the authors. Licensee MDPI, Basel, Switzerland. This article is an open access article distributed under the terms and conditions of the Creative Commons Attribution (CC BY) license (https://creativecommons.org/licenses/by/4.0/).
Share and Cite
Zhang, W.-J.; Li, S.; Yan, Y.-Z.; Park, S.S.; Mohan, A.; Chung, I.; Ahn, S.-k.; Kim, J.R.; Ha, C.-S. Dual (pH- and ROS-) Responsive Antibacterial MXene-Based Nanocarrier for Drug Delivery. Int. J. Mol. Sci. 2022, 23, 14925. https://doi.org/10.3390/ijms232314925
Zhang W-J, Li S, Yan Y-Z, Park SS, Mohan A, Chung I, Ahn S-k, Kim JR, Ha C-S. Dual (pH- and ROS-) Responsive Antibacterial MXene-Based Nanocarrier for Drug Delivery. International Journal of Molecular Sciences. 2022; 23(23):14925. https://doi.org/10.3390/ijms232314925
Chicago/Turabian StyleZhang, Wei-Jin, Shuwei Li, Yong-Zhu Yan, Sung Soo Park, Anandhu Mohan, Ildoo Chung, Suk-kyun Ahn, Jung Rae Kim, and Chang-Sik Ha. 2022. "Dual (pH- and ROS-) Responsive Antibacterial MXene-Based Nanocarrier for Drug Delivery" International Journal of Molecular Sciences 23, no. 23: 14925. https://doi.org/10.3390/ijms232314925





